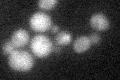
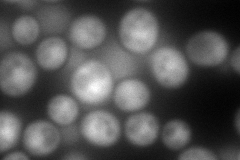
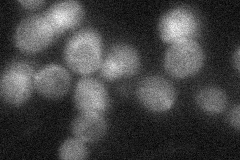
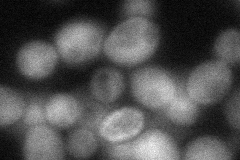

View description
Alpha subunit of both the farnesyltransferase and type I geranylgeranyltransferase that catalyze prenylation of proteins containing a CAAX consensus motif; essential protein required for membrane localization of Ras proteins and a-factor
Localization:
Intensity:
Fold change:
Significance:
-
C’ GFP library in SD
vacuole23.77 -
N' NOP1pr-GFP in SD

cytosol,nucleus190.935 -
N' TEF2pr-mCherry in SD
cytosol258.656 -
N' NATIVEpr-GFP in SD
below threshold25.8333 -
N' TEF2pr-VC and Cyto-VN in SD
cytosol54.0542 -
C’ GFP library in SD+DTT

vacuole20.370.85No -
C’ GFP library in SD+H2O2

vacuole18.80.79Yes -
C’ GFP library in Starvation Media

vacuole16.690.7Yes -
C’ GFP library on the background of Pup2-DaMP

vacuole -
C’ GFP library on the background of CCT mutant

vacuole22.50490.946236No
